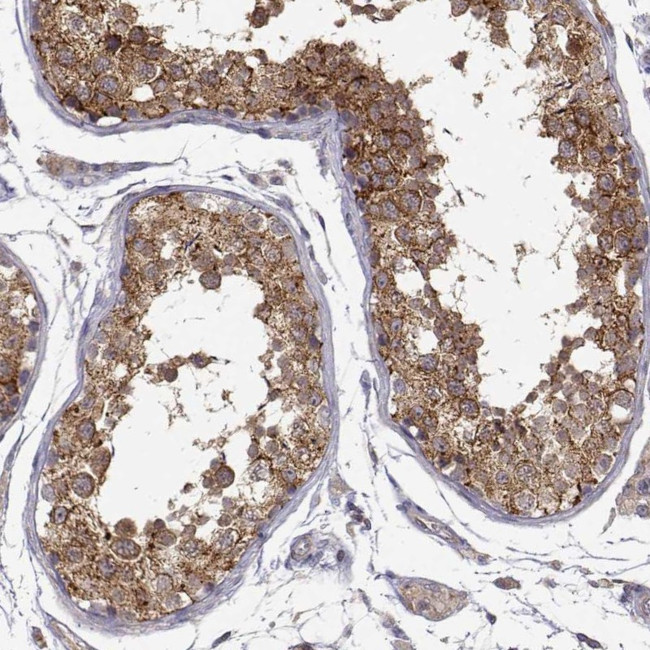
PAIP1 Antibody in Immunohistochemistry (Paraffin) (IHC (P))

Search
Invitrogen
PAIP1 Polyclonal Antibody
{{$productOrderCtrl.translations['antibody.pdp.commerceCard.promotion.promotions']}}
{{$productOrderCtrl.translations['antibody.pdp.commerceCard.promotion.viewpromo']}}
{{$productOrderCtrl.translations['antibody.pdp.commerceCard.promotion.promocode']}}: {{promo.promoCode}} {{promo.promoTitle}} {{promo.promoDescription}}. {{$productOrderCtrl.translations['antibody.pdp.commerceCard.promotion.learnmore']}}
产品信息
PA5-84934
种属反应
宿主/亚型
分类
类型
抗原
偶联物
形式
浓度
规格
纯化类型
保存液
内含物
保存条件
运输条件
RRID
产品详细信息
Immunogen sequence: GTNGQVTRAD ILQVGLRELL NALFSNPMDD NLICAVKLLK LTGSVLEDAW KEKGKMDMEE IIQRIENVVL DANCSRDVKQ MLLK
Highest antigen sequence indentity to the following orthologs: Mouse - 98%, Rat - 98%.
靶标信息
The protein encoded by this gene interacts with poly(A)-binding protein and with the cap-binding complex eIF4A. It is involved in translational initiation and protein biosynthesis. Overexpression of this gene in COS7 cells stimulates translation. Alternative splicing occurs at this locus and three transcript variants encoding three distinct isoforms have been identified.
仅用于科研。不用于诊断过程。未经明确授权不得转售。
篇参考文献 (0)
生物信息学
蛋白别名: PABC1-interacting protein 1; PABP-interacting protein 1; PAIP-1; Polyadenylate-binding protein-interacting protein 1; similar to central domain of eukaryotic initiation factor 4G
基因别名: PAIP1
UniProt ID: (Human) Q9H074
Entrez Gene ID: (Human) 10605